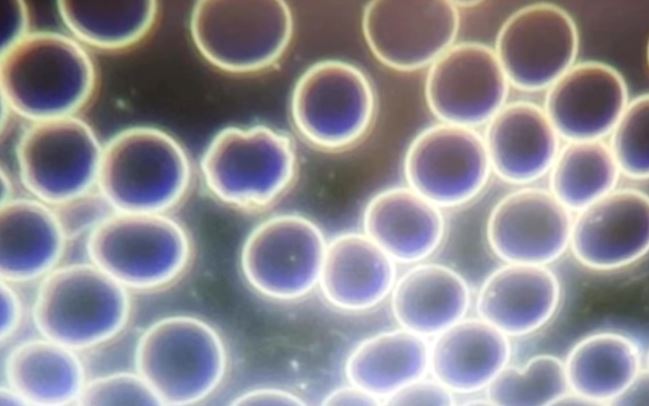
South Africa Zandrebotha Bloodwork Prevax

Living Document – First Published 8 April, 2022. Last Updated: June 2, 2022
This post is incomplete as the literature & evidence is endless so it may never be complete as it would need a team of people making it their permanent full-time role.
The “Time For The Truth On The Presence Of Graphene In The Shots” Post has now grown too big to edit (crashes the entire site whenever I edit it), so I’m removing most of the images and videos from this page – (they are still available on the full posts which are linked in each section).
Why we can’t “just trust”
What’s in the Vials?
Autopsies, Bloodwork / Exposure
The Dangers of Graphene
Evil Intent Concerns
Denying Graphene in the Vials
Graphene is in Everything
The Antidote
References/Footnotes:
- Pfizer Fights to Control Secret of $36 Billion Covid Vaccine Recipe – Bloomberg – Nov 15, 2021 ↥
- Pfizer warns Australia a Covid vaccine patent waiver could harm supply and safety – The Guardian, May 13, 2021 ↥
- Summary Basis for Regulatory Action – Nov 8, 2021 – FDA updated Document with “Water” included instead of the redacted ingredient ↥
- Physicians for Informed Consent – Instagram Post – Asking FDA why they redacted “water” and questioning why the math doesn’t add-up ↥
- ICAN – Hidden Ingredient in Pfizer Shot – Sept 2021 ↥
- ICAN – FOI Request for Redaction of Ingredients – PDF ↥
- Australian Government – Delegate’s Overview and Request for ACV’s Advice – BNT162b2 – Comirnaty (Pfizer) – TGA – FOI 2389 – PDF – Page 4 “As the safety follow up is currently limited to a median 2 months post-Dose 2, can ACV comment on the likelihood of vaccine-related AEs occurring after more than 2 months post vaccination, particularly with the new mRNA vaccine?” ↥
- Australian Government – Advisory Committee on Vaccines – BNT162b2 – Comirnaty (Pfizer) – TGA – FOI 2389 – Response – Page 11 “The ACV advised that it is unlikely for vaccine-related adverse events to occur more than 2 months after vaccination based on available data. ” PDF ↥
- Six Months Safety And Efficacy Of Pfizer “starting December 2020, participants were given the option of ‘unblinding’.“ ↥
- BMJ: Unclean Data In Vaccine Trials (Pfizer & FDA Should Be Investigated & Rollout Halted) “Researchers were testing Pfizer’s vaccine at several sites in Texas. A regional director, Brook Jackson has told The BMJ that the company “falsified data & unblinded patients“ ↥
- La Quinta Columna – Graphene Oxide in COVID Vaccines↥
- Download the new LA FIFTH COLUMN report “Identification of possible microtechnology and artificial patterns in Pfizer vaccine with optical microscopy” PDF – DropBox ↥↥
- Dropbox – FINAL TECHNICAL REPORT ON GRAPHENE DETECTION IN COVID VACCINES where the presence of Graphene Oxide is determined in the samples from Pfzer, Astrazeneca, Moderna and Janssen | Verify Document | ResearchGate ↥
- Interim Report ‘Graphene Oxide Detection in Aqueous Suspension’ ↥
- Download Dr Burkhardt’s tissue slides (PDF) ↥
- Long Circulating Nanoparticles for Sustained Release of Therapeutic Agents – US PATENT – US20100216804A1 ↥
- Karen Kingston – Biotech Analyst – PDF Presentation – Vaccine Patents ↥↥
- Docetaxel – Chemocare.com – Drug Info ↥
- Graphene oxide in contact with blood – Analysis ↥
- Palmieri, V.; Perini, G.; De Spirito, M.; Daddy, M. (2019). Graphene oxide touches blood: in vivo interactions of bio-coronated 2D materials. Nanoscale Horizons, 4(2), p. 273-290. https://doi.org/10.1039/C8NH00318A ↥
- Identification of patterns in blood of vaccinated persons: microswimmers ↥
- Identification of patterns in blood of vaccinated people: crystallized graphene ↥
- Blood exposure to graphene oxide can cause anaphylactic death in non-human primates ↥
- Identification of patterns in blood of vaccinated people: GQD graphene quantum dots ↥
- Wireless Nanocommunication Networks for Nanotechnology in the Human Body ↥
- Electromagnetic Nano-Networks Software ↥
- The CORONA routing system for nano-networks ↥
- Identification of patterns in coronavirus vaccines: carbon-graphene nanooctopuses and nanotubes ↥
- Identification of patterns in coronavirus vaccines: Mesoporous spheres ↥
- Identification of patterns in blood of vaccinated persons: Non-uniform multilayer graphene patches or graphene cracks ↥
- Rhazouani, Asmaa et al. “Synthesis and Toxicity of Graphene Oxide Nanoparticles: A Literature Review of In Vitro and In Vivo Studies.” BioMed research international vol. 2021 5518999. 10 Jun. 2021, doi:10.1155/2021/5518999 ↥
- Li Q, Zhang Z, Qi L, Liao Q, Kang Z, Zhang Y. Toward the Application of High Frequency Electromagnetic Wave Absorption by Carbon Nanostructures. Adv Sci (Weinh). 2019 Feb 10;6(8):1801057. doi: 10.1002/advs.201801057. PMID: 31016105; PMCID: PMC6468972. ↥
- Graphene oxide and the electromagnetic absorption of 5G – Analysis ↥
- Chen, Y.; Fu, X.; Liu, L.; Zhang, Y.; Cao, L.; Yuan, D.; Liu, P. (2019). Millimeter wave absorbing property of flexible graphene/acrylonitrile-butadiene rubber composite in 5G frequency band. Polymer-Plastics Technology and Materials, 58(8), 903-914. https://doi.org/10.1080/03602559.2018.1542714 | https://sci-hub.mksa.top/10.1080/03602559.2018.1542714 ↥
- Graphene oxide also absorbs 2G, 3G, 4G and 5G – Analysis ↥
- Ameer, S.; Gul, IH (2016). Influence of reduced graphene oxide on effective absorption bandwidth shift of hybrid absorbers. PLoS One, 11(6), e0153544. https://doi.org/10.1371/journal.pone.0153544 ↥↥
- Government of Spain. (2021). Recovery Plan, Transformation and Resilience. Component 15: Digital connectivity, promotion of cybersecurity and deployment of 5G. https://www.lamoncloa.gob.es/temas/fondos-recuperacion/Documents/16062021-Componente15.pdf ↥
- Behavior of graphene in EMF fields in-vivo and its relationship with neuromodulation ↥
- Manzo, L.P.; Ceragioli, H.; Bonet, IJ; Nishijima, C.M.; Scallop, WF; Oliveira, EC; Stop, CA (2017). Magnetic, but not non-magnetic, reduced graphene oxide in spinal cord increases nociceptive neuronal responsiveness. Nanomedicine: Nanotechnology, Biology and Medicine, 13(5), p. 1841-1851. https://doi.org/10.1016/j.nano.2017.02.019 ↥
- Radio-frequency characteristics of graphene oxide Appl. Phys. Lett. 97, 193103 (2010); https://doi.org/10.1063/1.3506468 ↥
- Biocompatibility and toxicity of graphene quantum dots for potential application in photodynamic therapy Tanveer A Tabish, Chris J Scotton, Daniel C J Ferguson, Liangxu Lin, Anienke van der Veen, Sophie Lowry, Muhammad Ali, Farhat Jabeen, Muhammad Ali, Paul G Winyard, and Shaowei ZhangNanomedicine 2018 13:15, 1923-1937 ↥
- Design of Wireless Nanosensor Networks for Intrabody Application Suk Jin Lee, Changyong (Andrew) Jung, Kyusun Choi, July 27, 2015 https://doi.org/10.1155/2015/176761 ↥
- Reports and Scientific Publications on the Toxicity of Graphene Oxide to Living Organisms and to Humans in Particular – Download PDF ↥
- Download a compendium of more than 60 scientific publications evaluating the Toxicity of Graphene Oxide in human biology ↥
- Dropbox – FINAL TECHNICAL REPORT ON GRAPHENE DETECTION IN COVID VACCINES where the presence of Graphene Oxide is determined in the samples from Pfzer, Astrazeneca, Moderna and Janssen | Verify Document | ResearchGate ↥
- Ou, Lingling et al. “Toxicity of graphene-family nanoparticles: a general review of the origins and mechanisms.” Particle and fibre toxicology vol. 13,1 57. 31 Oct. 2016, doi:10.1186/s12989-016-0168-y | PDF ↥
- Akhavan O, Ghaderi E. Toxicity of graphene and graphene oxide nanowalls against bacteria. ACS Nano. 2010 Oct 26;4(10):5731-6. doi: 10.1021/nn101390x. PMID: 20925398. ↥
- mRNA Vaccines = Gene Therapy – World Health Summit “We probably would have had a 95% refusal rate’ for these shots two years ago, but the pandemic and marketing of the injections as ‘vaccines’ has made them popular with the public” ↥
- Lieber, Charles 66 patents which are being used as scaffolds and wires and nanosensors and semiconductors in all vaccines as described here: https://patft.uspto.gov/netacgi/nph-Parser?Sect1=PTO2&Sect2=HITOFF&p=1&u=%2Fnetahtml%2FPTO%2Fsearch-bool.html&r=0&f=S&l=50&TERM1=%22Lieber%2C+Charles%22&FIELD1=INNM&co1=AND&TERM2=&FIELD2=&d=PTT ↥
- Justice.gov link to arrest of Charles Lieber (01-28-2020) https://www.justice.gov/opa/pr/harvard-university-professor-and-two-chinese-nationals-charged-three-separate-china-related ↥
- Justice.gov link to indictment of Charles Lieber (06-09-2020) https://www.justice.gov/opa/pr/harvard-university-professor-indicted-false-statement-charges ↥
- Patent US 7,858,965 – Nanowire Heterostructures https://patents.google.com/patent/US7858965B2/en – Charles Lieber ↥
- National Institute of Health’s grant AI23946-08, issued to Dr. Ralph Baric, funded by NIAID (Dr Anthony Fauci) ↥
- The Fauci/COVID-19 Dossier (PDF) ↥
- Fauci’s involvement in Corona Following The Patents: Covid-19 & Medical Tyranny (6 Feb 2022) ↥
- DARPA’s fascinating self-healing body initiative – ElectRx – Article – 20 Apr 2021 http://tisfightback.com/darpas-fascinating-self-healing-body-initiative-electrx ↥
- DARPA – Electrical Prescriptions (ElectRx) – https://www.darpa.mil/program/electrical-prescriptions ↥
- Graphene oxide disrupts mitochondrial homeostasis – Analysis ↥
- Xiaoli, F.; Yaqing, Z.; Ruhui, L.; Xuan, L.; Aijie, C.; Yanli, Z.; Longquan, S. (2021). Graphene oxide disrupted mitochondrial homeostasis through inducing intracellular redox deviation and autophagy-lysosomal network dysfunction in SH-SY5Y cells. cells. Journal of Hazardous Materials, 416, 126158. https://doi.org/10.1016/j.jhazmat.2021.126158 ↥
- Graphene oxide quantum dot-based memristors – Analysis ↥
- Yan, X.; Zhang, L.; Chen, H.; Li, X.; Wang, J.; Liu, Q.; Zhou, P. (2018). Graphene oxide quantum dots based memristors with progressive conduction tuning for artificial synaptic learning. Advanced Functional Materials, 28(40), 1803728. https://doi.org/10.1002/adfm.201803728 ↥
- Graphene oxide can adsorb and absorb CO2 ↥
- The spintronics of graphene Has Pandora’s box been uncovered here? ↥
- Article Graphene Biointerface Optically Controls Heart Cells ↥
- Article Manage laboratory-grown heart cells by remote control ↥
- Savchenko A, Cherkas V, Liu C, Braun GB, Kleschevnikov A, Miller YI, Molokanova E. Graphene biointerfaces for optical stimulation of cells. Sci Adv. 2018 May 18;4(5):eaat0351. doi: 10.1126/sciadv.aat0351. PMID: 29795786; PMCID: PMC5959318. ↥
- Interaction of graphene oxide with brain cells Analysis ↥
- Rauti, R.; Lozano, N.; Leon, V.; Scaini, D.; Musto, M.; Rago, I.; Ballerini, L. (2016). Graphene Oxide Nanosheets Reshape Synaptic Function in Cultured Brain Networks = Graphene Oxide Nanosheets Reshape Synaptic Function in Cultured Brain Networks. ACS Nano, 10(4), p. 4459-4471. https://doi.org/10.1021/acsnano.6b00130 ↥↥
- Mendonca, MCP; Soares, ES; de Jesus, MB; Ceragioli, H. J.; Batista, Â.G.; Nyúl-Tóth, Á.; da Cruz-Hofling, MA (2016). PEGylation of Reduced Graphene Oxide Induces Toxicity in Cells of the Blood–Brain Barrier: An in Vitro and in Vivo Study. Molecular Pharmaceuticals, 13(11), p. 3913-3924. https://doi.org/10.1021/acs.molpharmaceut.6b00696 ↥
- Graphene nanoparticles targeting siRNA delivery in the brain – Analysis ↥
- Joo, J.; Kwon, EJ; Kang, J.; Skalak, M.; Anglin, EJ; Mann, AP; Sailor, M.J. (2016). Porous silicon–graphene oxide core–shell nanoparticles for targeted delivery of siRNA to the injured brain. Nanoscale Horizons, 1(5), p. 407-414. https://doi.org/10.1039/C6NH00082G ↥
- Graphene oxide is able to overcome the blood-brain barrier and directly affect the brain- Analysis ↥
- Mendonca, MCP; Soares, ES; de Jesus, MB; Ceragioli, H. J.; Ferreira, MS; Catharino, R.R.; da Cruz-Höfling, MA (2015). Reduced graphene oxide induces transient blood–brain barrier opening: an in vivo study = Reduced graphene oxide induces transient blood–brain barrier opening: an in vivo study. Journal of nanobiotechnology, 13(1), p. 1-13. https://doi.org/10.1186/s12951-015-0143-z ↥↥
- Bai, H.; Li, C.; Wang, X.; Shi, G. (2010). A pH-sensitive graphene oxide composite hydrogel = A pH-sensitive graphene oxide composite hydrogel. Chemical Communications, 46(14), p. 2376-2378. https://doi.org/10.1039/C000051E ↥
- Baldrighi M.; Trusel M.; Tonini R.; Giordani S. (2016) Carbon nanomaterials interfacing with neurons: an in vivo perspective. Frontiers in neuroscience, 10, 250. https://doi.org/10.3389/fnins.2016.00250 ↥
- Campra, P. (2021). [Report]. Detection of graphene oxide in aqueous suspension (Comirnaty™ RD1): Observational study in light and electron microscopy. University of Almería. https://docdro.id/rNgtxyh ↥
- Hu, X.; Yu, Y.; Hou, W.; Zhou, J.; Song, L. (2013). Effects of particle size and pH value on the hydrophilicity of graphene oxide. Applied Surface Science, 273, pp. 118-121. https://doi.org/10.1016/j.apsusc.2013.01.201 ↥
- Mendonca, MCP; Soares, ES; de Jesus, MB; Ceragioli, H. J.; Batista, Â.G.; Nyúl-Tóth, Á.; da Cruz-Hofling, MA (2016a). PEGylation of Reduced Graphene Oxide Induces Toxicity in Cells of the Blood–Brain Barrier: An in Vitro and in Vivo Study. Molecular Pharmaceuticals, 13(11), p. 3913-3924. https://doi.org/10.1021/acs.molpharmaceut.6b00696 ↥
- Mendonca, MCP; Soares, ES; de Jesus, MB; Ceragioli, H. J.; Batista, Â.G.; Nyúl-Tóth, Á.; da Cruz-Hofling, MA (2016b) Reduced graphene oxide: nanotoxicological profile in rats = Reduced graphene oxide: nanotoxicological profile in rats. Journal of nanobiotechnology, 14(1), p. 1-13. https://doi.org/10.1186/s12951-016-0206-9 ↥
- Zhang, Y.; Ali, S.F.; Dervishi, E.; Xu, Y.; Li, Z.; Casciano, D.; Biris, AS (2010). Cytotoxicity effects of graphene and single-wall carbon nanotubes in neural phaeochromocytoma-derived PC12 cells ACS nano, 4(6), p. 3181-3186. https://doi.org/10.1021/nn1007176 ↥
- Neuroinflammation and neurodegenerative diseases caused by graphene oxide – Analysis ↥
- Chen, H. T.; Wu, H.Y.; Shih, CH; Jan, TR (2015). A differential effect of graphene oxide on the production of proinflammatory cytokines by murine microglia = A Differential Effect of Graphene Oxide on the Production of Proinflammatory Cytokines by Murine Microglia. Taiwan Veterinary Journal, 41(03), p. 205-211. https://doi.org/10.1142/S1682648515500110 | https://sci-hub.yncjkj.com/10.1142/S1682648515500110 ↥
- Chen, H. T.; Wu, H.Y.; Shih, CH; Jan, TR (2015). A differential effect of graphene oxide on the production of proinflammatory cytokines by murine microglia = A Differential Effect of Graphene Oxide on the Production of Proinflammatory Cytokines by Murine Microglia. Taiwan Veterinary Journal, 41(03), p. 205-211. https://doi.org/10.1142/S1682648515500110 ↥
- Dowaidar, M. (2021). Neuroinflammation caused by activated microglia and astrocytes may contribute to the progression of pathogenic damage to substantia nigra neurons, playing a role in the progression of Parkinson’s disease = Neuroinflammation caused by activated microglia and astrocytes can contribute to the progression of pathogenic damage to substantia nigra neurons, playing a role in Parkinson’s disease progression. https://osf.io/preprints/ac896/ ↥
- Graphene oxide and brain stimulation by electromagnetic waves EM capable of inferring in the human mind – Analysis ↥
- Li, X.; Xiong, H.; Rommelfanger, N.; Xu, X.; Youn, J.; Slesinger, PA; Qin, Z. (2021). Nanotransducers for wireless neuromodulation = Nanotransducers for wireless neuromodulation. Matter, 4(5), p. 1484-1510. https://doi.org/10.1016/j.matt.2021.02.012 ↥
- Beyene, AG; Delevich, K.; Del Bonis-O’Donnell, JT; Piekarski, D.J.; Lin, W.C.; Thomas, A.W.; Landry, MP (2019). Imaging striatal dopamine release using a nongenetically encoded near infrared fluorescent catecholamine nanosensor. Science advances, 5(7), eaaw3108. https://doi.org/10.1126/sciadv.aaw3108 ↥
- Bitterman, ME (2006). Classical conditioning since Pavlov = Classical conditioning since Pavlov. Review of General Psychology, 10(4), p. 365-376. https://doi.org/10.1037%2F1089-2680.10.4.365 ↥
- Chen, Y.; Fu, X.; Liu, L.; Zhang, Y.; Cao, L.; Yuan, D.; Liu, P. (2019). Millimeter wave absorbing property of flexible graphene/acrylonitrile-butadiene rubber composite in 5G frequency band. Polymer-Plastics Technology and Materials, 58(8), p. 903-914. https://doi.org/10.1080/03602559.2018.1542714 ↥
- Hernandez-Morales, M.; Shang, T.; Chen, J.; Han, V.; Liu, C. (2020). Lipid oxidation induced by RF waves and mediated by ferritin iron causes activation of ferritin-tagged ion channels. Cell reports, 30(10), p. 3250-3260. https://doi.org/10.1016/j.celrep.2020.02.070 ↥
- Huang, W.C.; Chi, H.S.; Lee, YC; Lo, YC; Liu, T. C.; Chiang, M.Y.; Chen, S.Y. (2019). Gene-Embedded Nanostructural Biotic–Abiotic Optoelectrode Arrays Applied for Synchronous Brain Optogenetics and Neural Signal Recording. ACS applied materials & interfaces, 11(12), p. 11270-11282. https://doi.org/10.1021/acsami.9b03264 ↥
- Koob, G.F. (1992). Dopamine, addiction and reward = Dopamine, addiction and reward. In Seminars in Neuroscience, 4(2), p. 139-148. https://doi.org/10.1016/1044-5765(92)90012-Q ↥
- Shepherd, J. (2015). Optogenetics in action: tiny wireless LEDs in mice let you control their neurons. Xataka. https://www.xataka.com/investigacion/la-optogenetica-en-accion-pequenos-leds-inalambricos-en-ratones-allow-control-their-neurons ↥
- Patriarchi, T.; Cho, JR; Merten, K.; Howe, MW; Marley, A.; Xiong, W. H.; Tian, L. (2018). Ultrafast neuronal imaging of dopamine dynamics with designed genetically encoded sensors. Science, 360(6396). https://doi.org/10.1126/science.aat4422 ↥
- Perini, G.; Palmieri, V.; Ciasca, G.; De Spirito, M.; Daddy, M. (2020). Unraveling the potential of graphene quantum dots in biomedicine and neuroscience. International Journal of Molecular Sciences, 21(10), 3712. https://doi.org/10.3390/ijms21103712 ↥
- Rastogi, S.K.; Garg, R.; Scopelliti, M.G.; Pinto, B. I.; Hartung, J.E.; Kim, S.; Cohen-Karni, T. (2020). Remote nongenetic optical modulation of neuronal activity using fuzzy graphene. Proceedings of the National Academy of Sciences, 117(24), p. 13339-13349. https://doi.org/10.1073/pnas.1919921117 ↥
- Ren, H.; Kulkarni, D.D.; Kodiyath, R.; Xu, W.; Choi, I.; Tsukruk, V.V. (2014). Competitive Adsorption of Dopamine and Rhodamine 6G on the Surface of Graphene Oxide. ACS Applied Materials & Interfaces, 6(4), p. 2459-2470. https://doi.org/10.1021/am404881p ↥
- Interfacing Graphene-Based Materials With Neural Cells Front. Syst. Neurosci., 11 April 2018 | https://doi.org/10.3389/fnsys.2018.00012 ↥
- Magnetogenetics, or the use of electromagnetic control, involves activating cells using magnetic fields. With magnetogenetics researchers have found a way to control neurons with electromagnets. https://www.noldus.com/applications/magnetogenetics ↥
- Engineering Brain Parasites for Intracellular Delivery of Therapeutic ProteinsShahar Bracha, Karoliina Hassi, Paul D. Ross, Stuart Cobb, Lilach Sheiner, Oded Rechavi bioRxiv 481192; doi: https://doi.org/10.1101/481192 ↥
- Ricardo Delgado Martin, Founder and Director of Quinta Columna. Ricardo is responsible for coordinating the Spanish research team’s analysis of the impacts of graphene oxide nano-particles contained in the vial of the mRNA vaccine. Ricardo Delgado Martin is specialized in biostatistics, clinical microbiology, clinical genetics and immunology. ↥
- Dropbox – FINAL TECHNICAL REPORT ON GRAPHENE DETECTION IN COVID VACCINES where the presence of Graphene Oxide is determined in the samples from Pfzer, Astrazeneca, Moderna and Janssen | Verify Document | ResearchGate | Interim Report ‘Graphene Oxide Detection in Aqueous Suspension ↥
- FINAL TECHNICAL REPORT ON GRAPHENE DETECTION IN COVID VACCINES where the presence of Graphene Oxide in the Pfzer, Astrazeneca, Moderna and Janssen samples is concluded. PDF – Dropbox ↥
- Graphene boosts GHz signals into terahertz territory – CORDIS – European Commission ↥
- Petition EN3128 – Verify whether Covid-19 vaccines contain Graphene Oxide ↥
- Ministerial response to petition: EN3128 – Min response – Health and Aged Care.pdf – 21 Nov 2021 | Hansard 14 Feb 2022 ↥
- Xue Y, Chen H, Yu D, Wang S, Yardeni M, Dai Q, Guo M, Liu Y, Lu F, Qu J, Dai L. Oxidizing metal ions with graphene oxide: the in situ formation of magnetic nanoparticles on self-reduced graphene sheets for multifunctional applications. Chem Commun (Camb). 2011 Nov 14;47(42):11689-91. doi: 10.1039/c1cc14789g. Epub 2011 Sep 26. PMID: 21952144. ↥
- Kharissova, O. V. , García, B. O. , IldusovichKharisov, B., & Méndez, U. O. (2016). Magnetic-Graphene-Based Nanocomposites and Respective Applications. In A. M. Silva, & S. A. Carabineiro (Eds.), Advances in Carbon Nanostructures. IntechOpen. https://doi.org/10.5772/64319 ↥
- Xu MQ, Wu JF, Zhao GC. Direct electrochemistry of hemoglobin at a graphene gold nanoparticle composite film for nitric oxide biosensing. Sensors (Basel). 2013 Jun 7;13(6):7492-504. doi: 10.3390/s130607492. PMID: 23748173; PMCID: PMC3715233. ↥
- Researchers Explore Graphene’s Potential Use in Nanotechnology – August 2017, Carnegie Mellon University News ↥
- Woo YS. Transparent Conductive Electrodes Based on Graphene-Related Materials. Micromachines (Basel). 2018 Dec 26;10(1):13. doi: 10.3390/mi10010013. PMID: 30587828; PMCID: PMC6356588. ↥
- Liao C, Li Y, Tjong SC. Graphene Nanomaterials: Synthesis, Biocompatibility, and Cytotoxicity. Int J Mol Sci. 2018 Nov 12;19(11):3564. doi: 10.3390/ijms19113564. PMID: 30424535; PMCID: PMC6274822.↥
- Tweedie MEP, Kersemans V, Gilchrist S, Smart S, Warner JH. Electromagnetically Transparent Graphene Respiratory Sensors for Multimodal Small Animal Imaging. Adv Healthc Mater. 2020 Nov;9(21):e2001222. doi: 10.1002/adhm.202001222. Epub 2020 Sep 23. PMID: 32965091. ↥
- Functionalized graphene oxide serves as a novel vaccine nano-adjuvant for robust stimulation of cellular immunity: https://pubs.rsc.org/en/content/articlelanding/2016/nr/c5nr09208f/unauth Xu et al., Nanoscale, 2016,8, 3785-3795 ↥
- “Functionalized graphene oxides (FGOs) show great potential as vaccine vectors and adjuvants. The combination of antigen and FGOs as vaccine formulation is a promising and important strategy for immunotherapy of various diseases.” https://www.sciencedirect.com/science/article/pii/S1742706120303305 ↥
- Huang, Haizhou et al. “Graphene-Based Sensors for Human Health Monitoring.” Frontiers in chemistry vol. 7 399. 11 Jun. 2019, doi:10.3389/fchem.2019.00399 ↥↥
- Trung TQ, Lee NE. Flexible and Stretchable Physical Sensor Integrated Platforms for Wearable Human-Activity Monitoringand Personal Healthcare. Adv Mater. 2016 Jun;28(22):4338-72. doi: 10.1002/adma.201504244. Epub 2016 Feb 3. PMID: 26840387. ↥
- Wang Z, Gao W, Zhang Q, Zheng K, Xu J, Xu W, Shang E, Jiang J, Zhang J, Liu Y. 3D-Printed Graphene/Polydimethylsiloxane Composites for Stretchable and Strain-Insensitive Temperature Sensors. ACS Appl Mater Interfaces. 2019 Jan 9;11(1):1344-1352. doi: 10.1021/acsami.8b16139. Epub 2018 Dec 19. PMID: 30523681. ↥
- Yang T, Jiang X, Zhong Y, Zhao X, Lin S, Li J, Li X, Xu J, Li Z, Zhu H. A Wearable and Highly Sensitive Graphene Strain Sensor for Precise Home-Based Pulse Wave Monitoring. ACS Sens. 2017 Jul 28;2(7):967-974. doi: 10.1021/acssensors.7b00230. Epub 2017 Jul 13. PMID: 28750520. ↥
- Highly Elastic Graphene-Based Electronics Toward Electronic Skin 2017 https://doi.org/10.1002/adfm.201701513 ↥
- Ameri SK, Singh PK, D’Angelo R, Stoppel W, Black L, Sonkusale SR. Three dimensional graphene scaffold for cardiac tissue engineering and in-situ electrical recording. Annu Int Conf IEEE Eng Med Biol Soc. 2016 Aug;2016:4201-4203. doi: 10.1109/EMBC.2016.7591653. PMID: 28269209. ↥
- Pu Z, Tu J, Han R, Zhang X, Wu J, Fang C, Wu H, Zhang X, Yu H, Li D. A flexible enzyme-electrode sensor with cylindrical working electrode modified with a 3D nanostructure for implantable continuous glucose monitoring. Lab Chip. 2018 Dec 7;18(23):3570-3577. doi: 10.1039/c8lc00908b. Epub 2018 Oct 30. PMID: 30376024. ↥
- Pang Y, Tian H, Tao L, Li Y, Wang X, Deng N, Yang Y, Ren TL. Flexible, Highly Sensitive, and Wearable Pressure and Strain Sensors with Graphene Porous Network Structure. ACS Appl Mater Interfaces. 2016 Oct 12;8(40):26458-26462. doi: 10.1021/acsami.6b08172. Epub 2016 Oct 3. PMID: 27684520. ↥
- Xu M , Qi J , Li F , Zhang Y . Highly stretchable strain sensors with reduced graphene oxide sensing liquids for wearable electronics. Nanoscale. 2018 Mar 15;10(11):5264-5271. doi: 10.1039/c7nr09022f. PMID: 29498389.↥
- Boland CS, Khan U, Backes C, O’Neill A, McCauley J, Duane S, Shanker R, Liu Y, Jurewicz I, Dalton AB, Coleman JN. Sensitive, high-strain, high-rate bodily motion sensors based on graphene-rubber composites. ACS Nano. 2014 Sep 23;8(9):8819-30. doi: 10.1021/nn503454h. Epub 2014 Aug 19. PMID: 25100211. ↥
- Pang Y, Zhang K, Yang Z, Jiang S, Ju Z, Li Y, Wang X, Wang D, Jian M, Zhang Y, Liang R, Tian H, Yang Y, Ren TL. Epidermis Microstructure Inspired Graphene Pressure Sensor with Random Distributed Spinosum for High Sensitivity and Large Linearity. ACS Nano. 2018 Mar 27;12(3):2346-2354. doi: 10.1021/acsnano.7b07613. Epub 2018 Feb 5. PMID: 29378401. ↥
- Park MVDZ, Bleeker EAJ, Brand W, Cassee FR, van Elk M, Gosens I, de Jong WH, Meesters JAJ, Peijnenburg WJGM, Quik JTK, Vandebriel RJ, Sips AJAM. Considerations for Safe Innovation: The Case of Graphene. ACS Nano. 2017 Oct 24;11(10):9574-9593. doi: 10.1021/acsnano.7b04120. Epub 2017 Sep 26. PMID: 28933820. ↥
- Kim J, Kim M, Lee MS, Kim K, Ji S, Kim YT, Park J, Na K, Bae KH, Kyun Kim H, Bien F, Young Lee C, Park JU. Wearable smart sensor systems integrated on soft contact lenses for wireless ocular diagnostics. Nat Commun. 2017 Apr 27;8:14997. doi: 10.1038/ncomms14997. PMID: 28447604; PMCID: PMC5414034. ↥
- Someya T, Bao Z, Malliaras GG. The rise of plastic bioelectronics. Nature. 2016 Dec 14;540(7633):379-385. doi: 10.1038/nature21004. PMID: 27974769. ↥
- Sathish kumar, Kamaraj. (2020). The Perspective on Bio-Nano Interface Technology for Covid-19. Frontiers in Nanotechnology. 2. 586250. 10.3389/fnano.2020.586250. ↥
- Graphene-based materials to combat COVID-19 – Analysis ↥
- Srivastava, AK; Dwivedi, N.; Dhand, C.; Khan, R.; Sathish, N.; Gupta, MK; Kumar, S. (2020). Potential of graphene-based materials to combat COVID-19: properties, perspectives and prospects. Materials Today Chemistry. https://doi.org/10.1016/j.mtchem.2020.100385 ↥
- Clothes with graphene oxide ↥
- All inkjet-printed graphene-based conductive patterns for wearable e-textile applications J. Mater. Chem. C, 2017,5, 11640-11648 https://doi.org/10.1039/C7TC03669H ↥
- “Graphene-coated face masks: COVID-19 miracle or another health risk?” May 5, 2021 – Phys.org ↥
- Graphene oxide in agriculture, the origin of the coronavirus? ↥
- Organic waste turned into graphene: high quality at a low price ↥
- Food packaging with graphene oxide. Patents and studies ↥
- Lactose-free dairy products and graphene oxide. Possible cause of lactose intolerance? ↥
- Smart Water Summit https://www.smartwatersummit.com ↥
- Milestone Contract For Graphene Technology In Water Treatment – 21 July 2021 – https://www.wateronline.com/doc/milestone-contract-for-graphene-technology-in-water-treatment-0001 ↥
- Bloomberg Profile – G2O Water Technologies Ltd https://www.bloomberg.com/profile/company/1679572D:LN ↥
- Graphene Smart membranes can Control Water and the latest on Graphene Membranes which is eye-opening in itself – https://phys.org/tags/graphene+membranes/ ↥
- Chemical clouds from the evaporation/volatilization/levitation of solutions with graphene and its ionization ↥
- Graphene oxide in aviation fuels https://corona2inspect.net/2021/08/06/graphene-oxide-in-aviation-fuels/ ↥
- Injection of graphene oxide aerosols into the atmosphere: Solar geoengineering and the role of aerogels https://corona2inspect.net/2021/08/09/injection-of-aerosols-of-graphene-oxide-in-the-atmosphere-la-geoingenieria-solar-y-el-rol-de-los-%20aerogels/ ↥
- Tropospheric Aerosol Geoengineering TAG: Radiometric Evidence from Chemtrails https://corona2inspect.net/2021/08/17/geoingenieria-de-aerosoles-troposfericos-tag-evidencia-radiometrica-de-los-chemtrails/ ↥
- Graphene oxide interferes in the nucleation of ice in the atmosphere https://corona2inspect.net/2021/08/04/graphene-oxide-infers-in-ice-nucleation-in-the-atmosphere/ ↥
- Graphene oxide in aerosol droplets – Analysis https://corona2inspect.net/2021/07/14/oxido-de-grafeno-en-gotas-de-aerosol/ ↥
- Wang, W. N.; Jiang, Y.; Biswas, P. (2012). Evaporation-induced crumpling of graphene oxide nanosheets in aerosolized droplets: confinement force relationship. Journal of Physical Chemistry, 3(21), p. 3228-3233. https://doi.org/10.1021/jz3015869 ↥
- Kim YH, Jo MS, Kim JK, et al. Short-term inhalation study of graphene oxide nanoplates. Nanotoxicology. 2018;12(3):224-238. doi:10.1080/17435390.2018.1431318 ↥
- Spray-on Nanoparticle Mix Turns Trees Into Antennas (2012) – Video by Manufacturer of Technology https://odysee.com/@Docuteca:5/Anthony-Sutera-on-low-power-wireless-everywhere:3 ↥
- Lv, B., Liu, Y., Wu, W. et al. Local large temperature difference and ultra-wideband photothermoelectric response of the silver nanostructure film/carbon nanotube film heterostructure. Nat Commun 13, 1835 (2022). https://doi.org/10.1038/s41467-022-29455-6 ↥
- “Supplementing with zinc reduces mortality and recovery time in Covid” Researchers show that the supplementation of this substance improves the prognosis of patients infected with the virus – in Spanish ↥
- Importance of Zinc for the treatment of COVID-19. – Spanish ↥
- Lactic acid bacteria could protect from the toxicity of graphene oxide in the intestine – Analysis ↥
- Zhao, Y.; Yu, X.; Jia, R.; Yang, R.; Rui, Q.; Wang, D. (2015). Lactic acid bacteria protects Caenorhabditis elegans from toxicity of graphene oxide by maintaining normal intestinal permeability under different genetic backgrounds. Scientific reports, 5(1), p. 1-13. https://doi.org/10.1038/srep17233 ↥
- Graphene oxide biodegrades with help of human enzymes Article: phys.org ↥
- “Dispersibility-dependent biodegradation of graphene oxide by myeloperoxidase,” Small, 8 May 2015; DOI: 10.1002/smll.201500038 ↥
- Kurapati R, Russier J, Squillaci MA, Treossi E, Ménard-Moyon C, Del Rio-Castillo AE, Vazquez E, Samorì P, Palermo V, Bianco A. Dispersibility-Dependent Biodegradation of Graphene Oxide by Myeloperoxidase. Small. 2015 Aug 26;11(32):3985-94. doi: 10.1002/smll.201500038. Epub 2015 May 8. PMID: 25959808. ↥
- Mukherjee et al. Graphene oxide is degraded by neutrophils, and the degradation products are non-genotoxic. Nanoscale. 2018 Jan 18;10(3):1180-1188. doi: 10.1039/c7nr03552g. PMID: 29271441. ↥
- R. Kurapati, S. P. Mukherjee, C. Martín, G. Bepete, E. Vázquez, A. Pénicaud, B. Fadeel, A. Bianco, Angew. Degradation of Single-Layer and Few-Layer Graphene by Neutrophil Myeloperoxidase. Chem. Int. Ed. 2018, 57, 11722. ↥
- Biodegradation of carbon nanohorns in macrophage cells Nanoscale, 2015,7, 2834-2840 ↥
- Ahmad, Shama et al. “Acute pulmonary effects of aerosolized nicotine.” American journal of physiology. Lung cellular and molecular physiology vol. 316,1 (2019): L94-L104. doi:10.1152/ajplung.00564.2017 ↥
- Bridges RB, Fu MC, Rehm SR. Increased neutrophil myeloperoxidase activity associated with cigarette smoking. Eur J Respir Dis. 1985 Aug;67(2):84-93. PMID: 2996923. ↥
- Biodegradation of Single-Walled Carbon Nanotubes through Enzymatic Catalysis Brett L. Allen, Padmakar D. Kichambare, Pingping Gou, Irina I. Vlasova, Alexander A. Kapralov, Nagarjun Konduru, Valerian E. Kagan, and Alexander StarNano Letters 2008 8 (11), 3899-3903DOI: 10.1021/nl802315h ↥
- Zhang, M., Deng, Y., Yang, M. et al. A Simple Method for Removal of Carbon Nanotubes from Wastewater Using Hypochlorite. Sci Rep 9, 1284 (2019). https://doi.org/10.1038/s41598-018-38307-7 ↥
- Shrivastava, Shubham et al. “Elevated Levels of Neutrophil Activated Proteins, Alpha-Defensins (DEFA1), Calprotectin (S100A8/A9) and Myeloperoxidase (MPO) Are Associated With Disease Severity in COVID-19 Patients.” Frontiers in cellular and infection microbiology vol. 11 751232. 21 Oct. 2021, doi:10.3389/fcimb.2021.751232 ↥
- Barnes BJ, Adrover JM, Baxter-Stoltzfus A, Borczuk A, Cools-Lartigue J, Crawford JM, Daßler-Plenker J, Guerci P, Huynh C, Knight JS, Loda M, Looney MR, McAllister F, Rayes R, Renaud S, Rousseau S, Salvatore S, Schwartz RE, Spicer JD, Yost CC, Weber A, Zuo Y, Egeblad M. Targeting potential drivers of COVID-19: Neutrophil extracellular traps. J Exp Med. 2020 Jun 1;217(6):e20200652. doi: 10.1084/jem.20200652. PMID: 32302401; PMCID: PMC7161085. – CHECK OUT THE CONFLICT$!! Then see related studies — but always check the conflict$ and notice how they are all referencing each other ↥
- Khan, Amjad A et al. “Myeloperoxidase as an Active Disease Biomarker: Recent Biochemical and Pathological Perspectives.” Medical sciences (Basel, Switzerland) vol. 6,2 33. 18 Apr. 2018, doi:10.3390/medsci6020033 ↥
- Girish CM, Sasidharan A, Gowd GS, Nair S, Koyakutty M. Confocal Raman imaging study showing macrophage-mediated biodegradation of graphene in vivo. Adv Healthc Mater. 2013 Nov;2(11):1489-500. doi: 10.1002/adhm.201200489. Epub 2013 Apr 2. PMID: 23554400. ↥
- Information Guide for Vaccinated & Unvaccinated people – Magnetism, graphene oxide nanoparticles, COVID-19 – La Quinta Columna – PDF – DropBox ↥
- Bhattacharya K, Mukherjee SP, Gallud A, Burkert SC, Bistarelli S, Bellucci S, Bottini M, Star A, Fadeel B. Biological interactions of carbon-based nanomaterials: From coronation to degradation. Nanomedicine. 2016 Feb;12(2):333-51. doi: 10.1016/j.nano.2015.11.011. Epub 2015 Dec 17. PMID: 26707820; PMCID: PMC4789123. ↥
Site Notifications/Chat:
- Telegram Post Updates @JourneyToABetterLife (channel)
- Telegram Chatroom @JourneyBetterLifeCHAT (say hi / share info)
Videos: